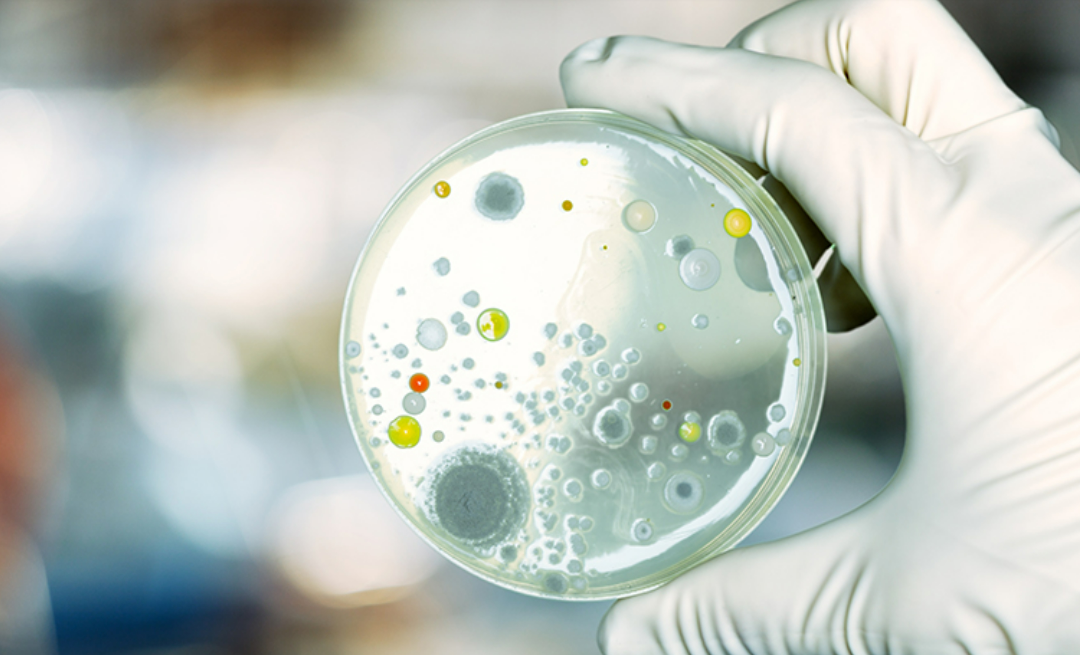
Laboratório de Microbiologia Experimental e Aplicada do campus de Nova Friburgo da UFF colabora com o desenvolvimento da ciência biomédica brasileira

A Universidade Federal Fluminense foi agraciada com o certificado de menção honrosa na 4ª edição do Prêmio Interamericano de Modelos Educacionais Inovadores no Ensino Superior (MEIN), realizado pela Organização Universitária Interamericana OUI-IOHE, em conjunto com a George Mason University. O...
Foi inaugurado hoje, 10, o Centro Holográfico de Saúde do Hospital Universitário Antônio Pedro (Huap-UFF), uma iniciativa que uniu as áreas da medicina e da engenharia para levar a tecnologia de ponta para os atendimentos em telessaúde da unidade hospitalar. O objetivo é facilitar o diagnóstico de...
Frente ao atual cenário epidemiológico da Covid-19 e a maior circulação das novas variantes do vírus no estado do Rio de Janeiro, a Universidade Federal Fluminense, por meio do GT Covid-19 UFF, publicou recentemente o Informe Técnico 16/2022 com orientações à comunidade acadêmica. Destacam-se como...
Como parte das celebrações do mês da Consciência Negra e da luta antirracista, o Centro de Artes da Universidade Federal Fluminense convida para o evento “Atelerió – afropresenças e luta”, entre os dias 17 e 23 de novembro de 2022. O encontro vai reunir intelectuais, artistas, coletivos e...
“Araci”, nome que em Tupi-Guarani significa “aurora”, possui também o significado de oportunidade. Através da Incubadora de Projetos de Cinema e Audiovisual da Universidade Federal Fluminense, novas gerações de cineastas encontram terreno fértil para poderem se desenvolver....
A ciência é uma das maiores ferramentas de decodificação do mundo. A pesquisa científica, que tem como premissa o comprometimento com o desenvolvimento das sociedades, conta com a participação fundamental das mulheres, que, segundo o CNPq, representam 43,7% dos pesquisadores no Brasil. Todavia,...
A Universidade Federal Fluminense está realizando mais uma edição do Pint of Science, evento que leva o conhecimento científico para a mesa de bar. Depois de dois anos em formato online, o Pint of Science acontece em Niterói e em Volta Redonda, nos dias 07, 08 e 09 de novembro de 2022. O Festival...
As miocardiopatias, nome dado a doenças que envolvem o músculo cardíaco, constituem atualmente a principal indicação de transplante cardíaco em crianças maiores de um ano de idade. Apesar de pouco frequentes nessa faixa etária e também entre adolescentes, a sua presença pode dar origem a...
A expressão “ação empreendedora” remete ao comportamento de pessoas que buscam soluções e enxergam oportunidades mesmo em um cenário com riscos e conflitos. Não à toa, esse conceito está presente no cerne da Enactus UFF, organização sem fins lucrativos e também um projeto de extensão criado por...
A Universidade Federal Fluminense inaugurou o novo prédio do Instituto de Geociências, no bloco P, do campus da Praia Vermelha, em Niterói. O evento aconteceu na manhã de sexta-feira, dia 21 de outubro, e contou com a presença do reitor da UFF, professor Antonio Claudio Lucas da Nóbrega, gestores...
Na última semana, a Universidade Federal Fluminense inaugurou quatro novos espaços na UFF de Volta Redonda: o Espaço das Empresas Juniores, o Espaço das Associações Atléticas, a Sala de Inclusão e Acessibilidade e a Quadra Poliesportiva Multiuso com Palco Cultural. A luta por investimento em...
O Laboratório de Microbiologia Experimental e Aplicada do campus de Nova Friburgo da Universidade Federal Fluminense (UFF) possui linhas de pesquisa voltadas para o estudo da virulência bacteriana, ou seja, estruturas e substâncias produzidas por micro-organismos que, apesar de causarem danos ao...
A preservação da história, memória e identidade de Niterói acaba de ganhar um novo acervo público, com registros fotográficos e audiovisuais que atravessam mais de um século, digitalizados em alta qualidade. O material será disponibilizado para acesso gratuito e online para a população. O projeto...
Niterói tem sua tradição no mar. Seja na cultura, em esportes, no estilo de vida ou nas atividades econômicas, trata-se de parte fundamental da cidade. Unindo tradição e um olhar para o futuro, o município atualmente vive um processo de revitalização da sua atividade marítima, com ênfase nos...
O Vírgula Hub de Inovação VR é um espaço físico e virtual de interação entre universidades, empresas, governos e sociedade para o exercício do empreendedorismo inovador e a realização de negócios visando o desenvolvimento socioeconômico regional. A ideia partiu da parceria entre a Prefeitura...
Depois da pandemia, do distanciamento social e tantos outros desafios vividos nos últimos anos e atualmente, o que poderemos (re)encontrar na Agenda Acadêmica da Universidade Federal Fluminense (UFF)? Encontros e reencontros seguem fazendo parte da história da universidade, como se verá nesta...
“A gente quer comida, diversão e arte”: a canção dos Titãs nos lembra que a fome do povo vai além de comida. É também fome de democracia, diversão e felicidade, e aponta o acesso à cultura como um direito de todos(as) que deve ser garantido. Num cenário de tantos retrocessos, Niterói caminha na...
No planeta, há uma grande incidência de energia limpa e renovável proporcionada pelo Sol. Além de trazer luz, necessária para a vida na Terra, esses raios também podem ser utilizados para a geração energética, tanto na forma de calor quanto na de eletricidade. É a partir desse mecanismo, possível...
O debate sobre mudanças climáticas já não é mais novidade, principalmente no que se refere à vulnerabilidade, que traz prejuízos ambientais e sociais ao redor do mundo. Os países em desenvolvimento são, particularmente, mais suscetíveis a essas mudanças. Dentre muitos fatores envolvidos, as...
O Colégio Universitário Geraldo Achilles Reis (Coluni) vai ter, pela primeira vez, um ônibus próprio para o transporte dos estudantes da unidade. A entrega do veículo acontece na segunda-feira, dia 10 de outubro, e reforça a capacidade institucional de atender às demandas da comunidade interna....